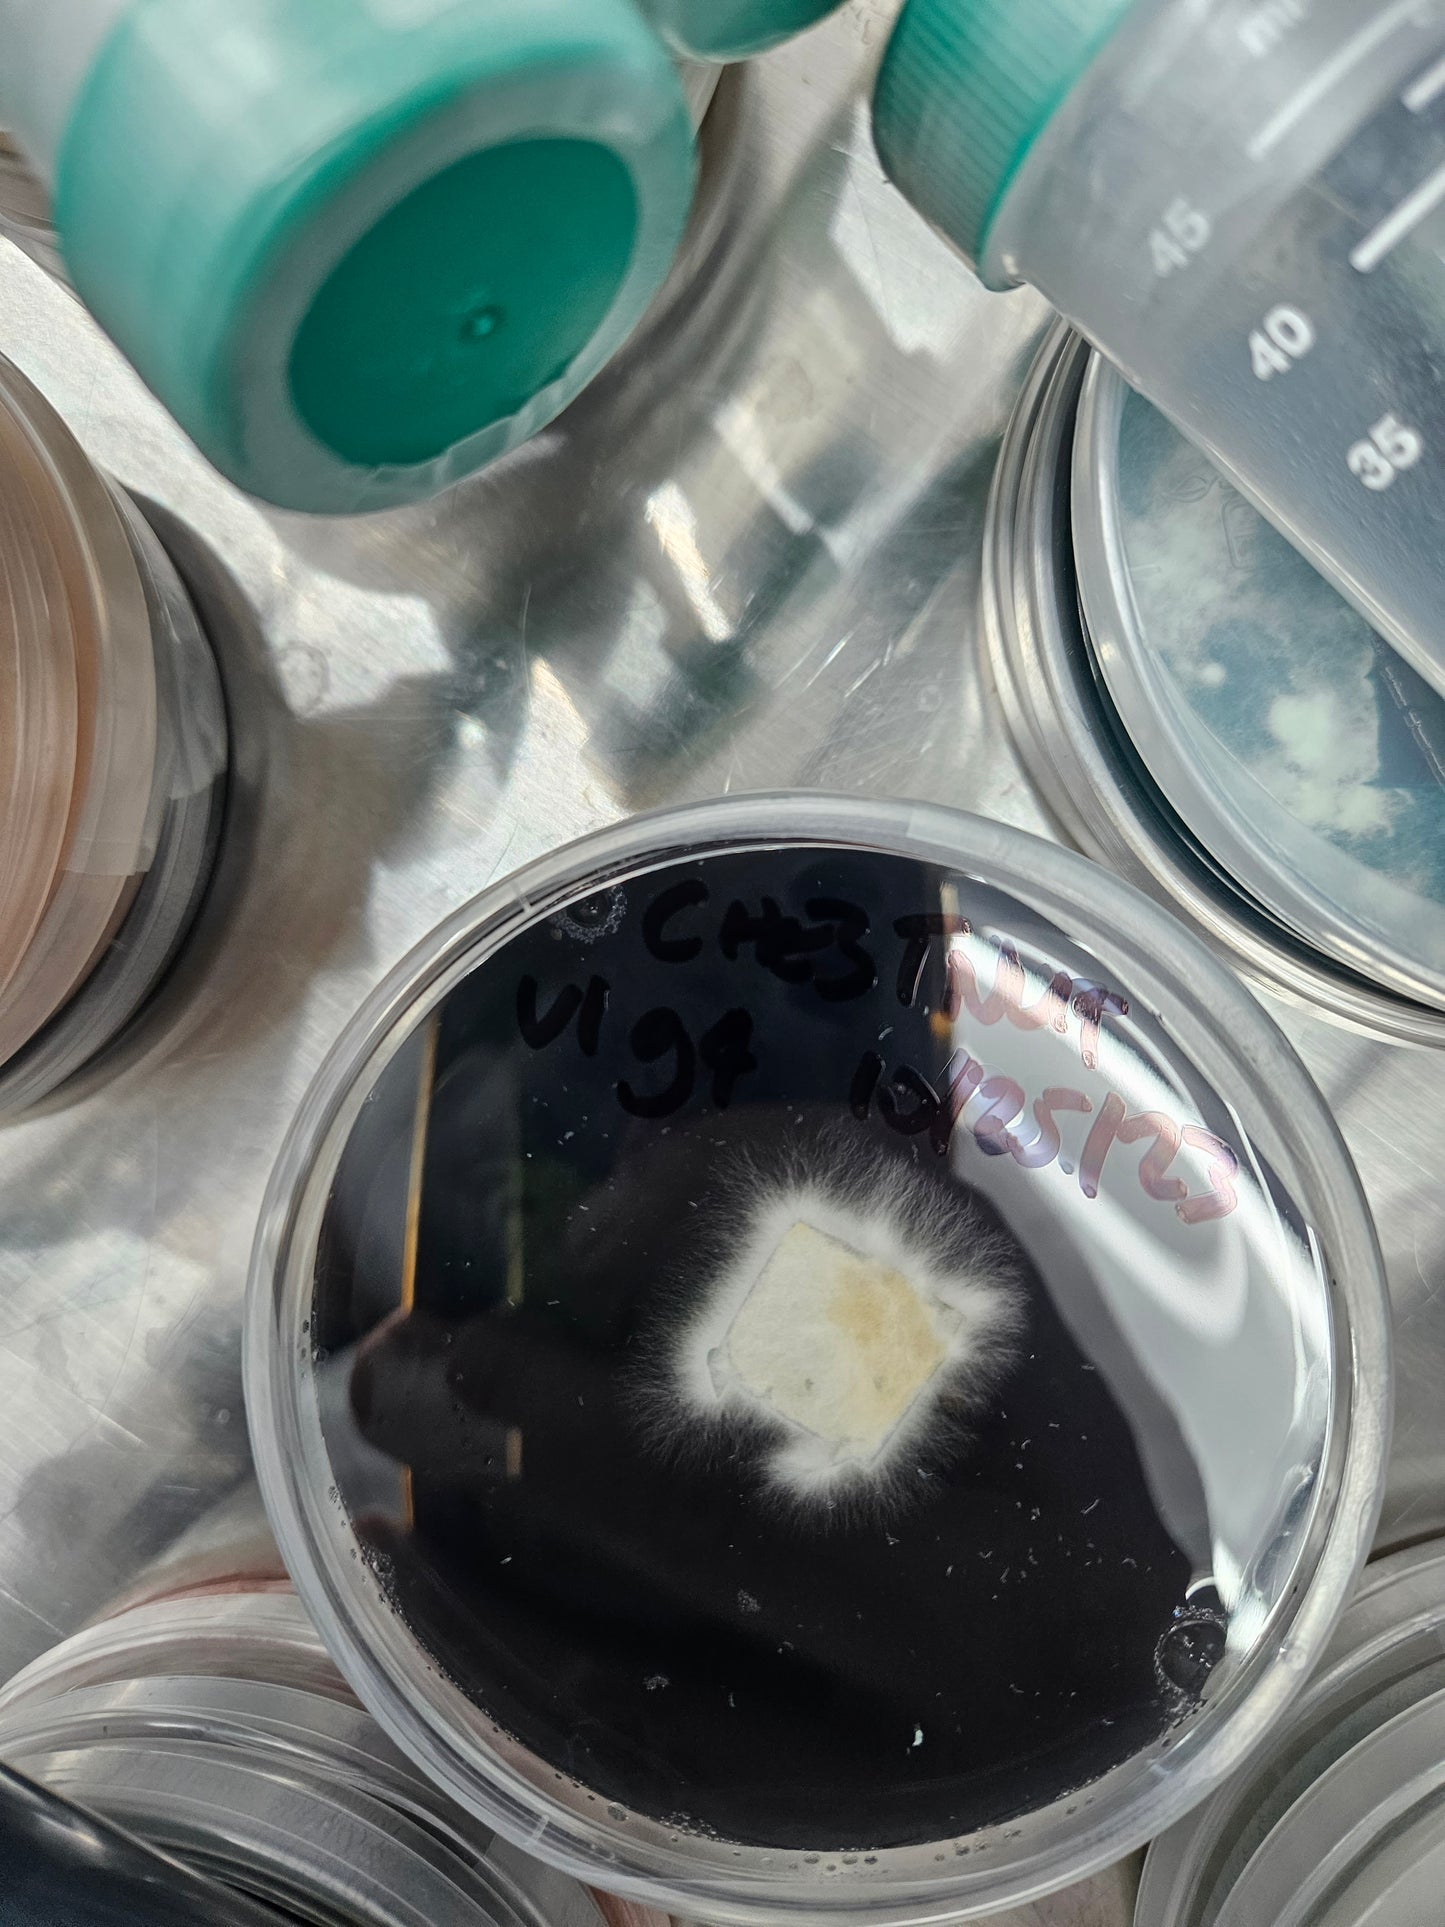

Nutrient Agar Mix - 100g
Nutrient Agar Mix - 100g
Couldn't load pickup availability
Our proprietary nutrient agar mix promotes rapid growth, longevity, and makes viewing a breeze.
The dark coloration is for contrast to the mycelium, we use organic activated charcoal, it is also doubles as fuel for mycelium, and will over time be consumed, giving and indication of remaining food source. With over 9 different nutrient amendments in our recipe we sourced only the highest grade ingredients, and tested over 45 recipe configurations before offering this specific variation for sale.
To be used in the production of culture slants and petri dishes, this is what we use exclusively in our lab and production center.
Makes 3.64L of Nutrient Agar, about 160-220 petri dishes depending on fill rate in a 90mm diameter petri dish or 100 culture slants (35ml each).
Share